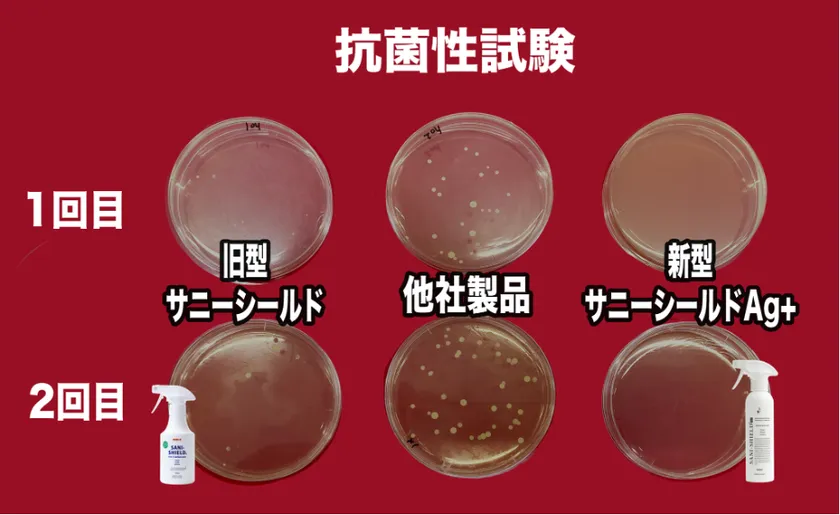
抗菌性試験の比較(左から弊社旧製品・他社製品・弊社新製品)

株式会社エイチ・アンド・ジェイ(以下、当社)は、岐阜大学応用生物科学部 岩橋均 名誉教授(株式会社エイチ・アンド・ジェイ顧問)らによる研究発表(2025年3月公表)をもとに、抗菌技術を語るうえで重要となる「評価法(測り方)」に焦点を当てた情報公開を開始します。
本件の主題は、「経時変化を観察する」という評価法です。これまで広く用いられてきた国際標準で定められた評価方法は、ある時点での生き残った微生物やウイルスの数を測定するという手法です。この手法では微生物やウイルスが塊を作った場合にも抗菌性があるという判定がなされます。例えば酸化チタン粒子は水の中に入るとお互いに凝集し、加えて微生物やウイルスを凝集させて塊を形成します。微生物の個数を評価する手法では、100個の微生物が2個の塊になると微生物が2個になったと判定され、見かけ上抗菌性が認められることになります。ある時点だけではなくその後も数を数える、すなわち「経時変化を観察する」と、2個の塊の中で微生物が生きていると再度2個と判定されます。本当に抗菌性があると0個になるはずです。
■ 1. 新しい評価視点:抗菌性を「経時変化」という視点で評価する
岐阜大学の発表では、従来の国際標準の評価法とは異なる発想として「高い抗菌性がある場合にのみ有効と判断できる(強い抗菌性を見抜く)」評価法の考え方が提示されています。
これにより、以下の手法を経時的に繰り返して菌を比較することで、経時変化による抗菌性の高さを判定することができます。
実際にこの手法で市販の抗菌噴霧剤を調査したところ、驚くことに多くの市販品には抗菌性が認められませんでした。

新評価手法の模式図(理解促進のための図解)
■ 2. なぜ「凝集」が評価に影響を与えるのか
酸化チタンの抗菌や光触媒の議論では、ある時点での「菌の個数」で評価を行うため、多くの場合に抗菌性があると評価されていました。そのため、菌の大きさや時間経過に伴う効き方の変化(持続性)、日常環境に存在する汚れ(油分や有機物など)の影響は検証していませんでした。
当社は、岐阜大学にて公開された新手法、すなわち凝集と経時変化を考慮した評価手法を採用することが、実際の使用環境における効果の有無や持続性について重要であると考えています。

菌の凝集による検査結果への影響/実際の環境で阻害される効果
■ 3. 比較結果の一例
以下は、新しい評価法の考え方に沿って実施した抗菌性を示す比較図です。
従来の評価法の場合、単一の時間経過では菌の凝集により菌が減っている(抗菌性がある)と判定されていました。しかし、経時変化と菌の凝集に着目する新手法では、その後の変化により本質的な抗菌性の有無を確認することができました。
この手法により、国際評価基準で抗菌性があると評価されている製品よりも、高性能な製品であることを評価することもできます。

従来法と新手法の比較(酸化チタン/銀イオンの結果例)
■ 4. 補足:新しい評価基準で高い評価を得た「サニーシールドAg+」を開発
当社では、新しい評価法において高い抗菌性を有する商品として、洗浄/除菌と同時にコーティングを行う抗菌噴霧剤「サニーシールドAg+」を開発しました。既存商品でも従来の評価法では一定の効果があると判定されていますが、新評価法によれば、十分な効果が確認できていない場合があることが把握されてきました。この新評価法の採用を奇貨として、より公衆衛生に貢献できる製品の開発に尽力して参ります。
抗菌性試験の比較(左から弊社旧製品・他社製品・弊社新製品)
■ 関連情報
岐阜大学応用生物科学部 岩橋均 名誉教授らによる研究発表(2025年3月)
https://www.gifu-u.ac.jp/news/research/2025/03/entry11-14258.html
日本規格協会の記事「噴霧式抗菌技術の機能向上」(2025年9月)



















